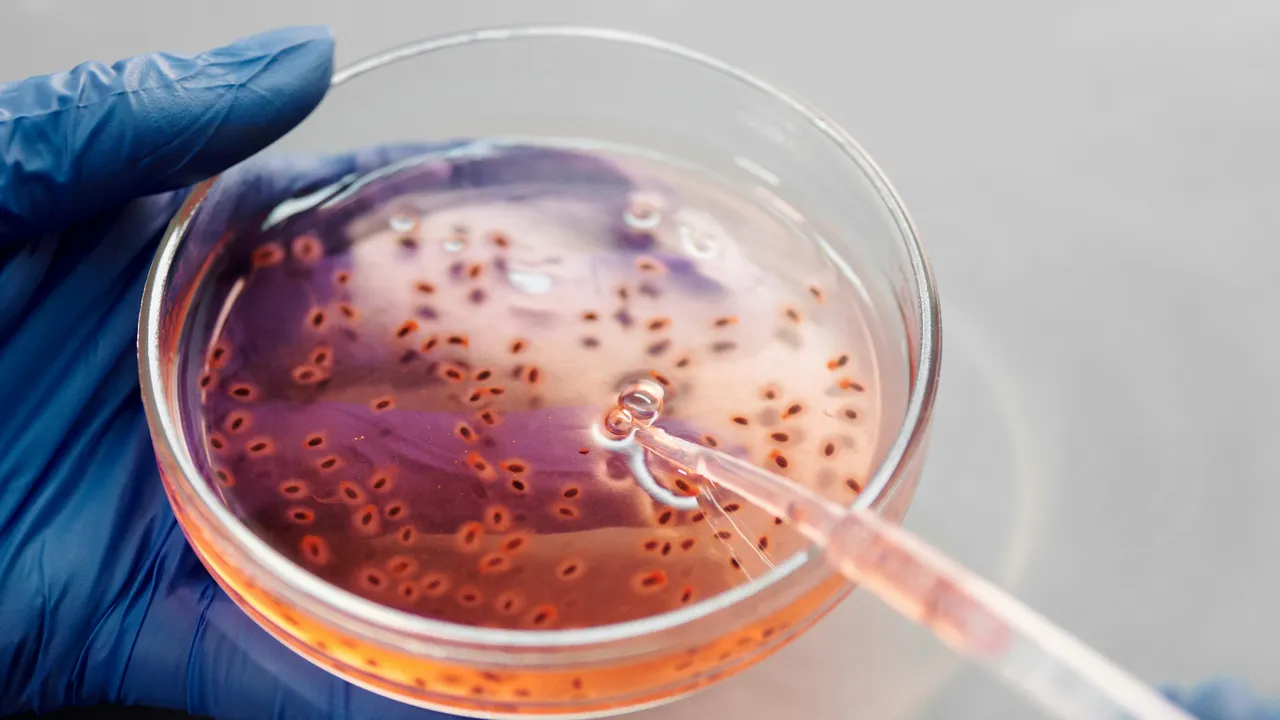
50 bin dolar karşılığında bebeklerinin genetiğini seçiyorlar! Skandal uygulama

"Özel okuldan daha ucuz" 50 bin dolar karşılığında bebeklerinin genetiğini seçiyorlar!

The Guardian’ın haberine göre, İngiltere’de tüp bebek tedavisi gören çiftlerin, embriyolarını genetik tahminlere dayalı olarak potansiyel zekâ (IQ), boy ve sağlık durumlarına göre sıralamak için yasal bir boşluğu kullandığı ortaya çıktı. Ancak, embriyoları DNA'larına göre puanlayan bu tartışmalı tarama tekniği, İngiltere’de yasal değil. Bilim insanları yöntemin bilimsel olarak kanıtlanmandığını ve etik açıdan sakıncalı olduğunu belirtiyor.

Ancak, İngiltere'deki veri koruma yasaları sayesinde hastalar, embriyolarının ham genetik verilerini talep edebiliyor ve daha "zeki" ve "sağlıklı" çocuklar dünyaya getirme amacıyla yurt dışındaki laboratuvarlara analize gönderebiliyor.

“TÜP BEBEK KLİNİKLERİ HUKUKİ VE ETİK KAOS İÇERİSİNDE”
Londra'daki Avenues adlı tüp bebek kliniğinin kurucusu Dr. Cristina Hickman, poligenik tarama tekniklerindeki hızlı ilerlemelerin ve ABD merkezli Herasight gibi şirketlerin hizmete girmesinin, kliniklerde "hukuki ve etik bir karmaşaya" yol açtığını söyledi. Hickman, bu konuyu geçen ay İnsan Döllenme ve Embriyoloji Kurumu'na (HFEA) yazdığı bir mektupta da gündeme getirdi.
"50 BİN DOLARA EMBRİYO DNA'SI ANALİZİ"
Sınırsız sayıda embriyoyu değerlendirmek için 50 bin dolar (yaklaşık 2 milyon lira) talep eden ABD’li şirket Herasight, İngiltere’deki kliniklerde IVF tedavisi gören çiftlerle çalıştığını doğruladı. Şirketin herhangi bir düzenlemeyi ihlal ettiğine dair bir iddia bulunmuyor.

Avenues Kliniği’nde, kliniğin katılımı olmaksızın Herasight hizmetini kullanmayı planlayan iki hasta bulunuyor. Bu hastalardan biri olan 29 yaşındaki kadın, eşiyle birlikte diyabet gibi hastalık risklerini azaltmayı ve yüksek tahmini IQ puanına sahip embriyoları seçmeyi umduklarını belirtti.

"ÖZEL OKUL ÜCRETİNDEN DAHA AZ"
Anonim kalmak isteyen hasta, "İnsanlar çocuklarına doğumdan sonra biraz daha iyi hayatlar sunmak için çok para ve acı harcamaya istekliler. Bu, yaptığınız yatırımın karşılığını en iyi alacağınız yol gibi görünüyor; yıllık özel okul ücretinden daha az" diye konuştu.

HERASİGHT NE İDDİA EDİYOR?
Herasight, beş embriyosu olan bir çift için ortalama altı IQ puanı kazancı sağladığını iddia ediyor ve kalp hastalığı, yaygın kanserler, Alzheimer ve şizofreni dahil olmak üzere çeşitli durumlar için cinsiyet, tahmini boy ve risk puanları sunuyor.

İNGİLTERE'DEKİ YASAL DURUM
İngiltere’de embriyolar üzerinde yapılan testler yasal olarak Huntington, orak hücre anemisi veya kistik fibroz gibi ciddi sağlık sorunlarının listesiyle sınır bulunuyor. Kliniklerin embriyo seçimi amacıyla poligenik tarama yapması ise yasak. HFEA ayrıca, bir klinisyenin, hastanın puan bilgisine dayanarak hangi embriyonun kullanılacağı konusunda hastanın yönlendirmesine uymaması gerektiğini belirtiyor.

ETİK TARTIŞMALAR VE ENDİŞELER
Herasight, algoritmalarını İngiliz Biobank da dahil olmak üzere büyük genetik veri tabanlarını kullanarak geliştirdiğini ve tahminlerinin bilimsel dayanağını yayınladığını belirtse de, poligenik puanların embriyo seçiminde kullanılması tartışmalı olmaya devam ediyor. Avrupa Genetik Derneği bu tekniği "kanıtlanmamış ve etik dışı" olarak kınadı.

Daha geniş etik endişeler arasında, daha varlıklı insanların tercih ettikleri embriyoları seçmek için para ödediği katmanlı bir toplum potansiyeli ve bazı bireylerin genetik olarak daha üstün olduğu inancının normalleşmesi riski de yer alıyor. Cardiff Üniversitesi'nden klinik genetik uzmanı Prof. Angus Clarke, "Bu şirketler, duygusal olarak gergin bir bağlamda belirsiz bir bilimle uğraşıyorlar" diyerek, ebeveynlerin "herhangi bir çocuk yerine mümkün olan en iyi çocuğu" seçme vaadine karşı koymakta zorlanabileceğini ekledi.


















